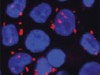

- NEWS AND VIEWS
Microbial molecule of ageing gut nudges blood stem cells towards cancer
Access options
Access Nature and 54 other Nature Portfolio journals
Get Nature+, our best-value online-access subscription
$32.99 / 30 days
cancel any time
Subscribe to this journal
Receive 51 print issues and online access
$199.00 per year
only $3.90 per issue
Rent or buy this article
Prices vary by article type
from$1.95
to$39.95
Prices may be subject to local taxes which are calculated during checkout
Nature 642, 39-41 (2025)
doi: https://doi.org/10.1038/d41586-025-01137-5
References
Orkin, S. H. Nature Rev. Genet. 1, 57–64 (2000).
Agarwal, P. et al. Nature 642, 201–211 (2025).
Jaiswal, S. et al. N. Engl. J. Med. 371, 2488–2498 (2014).
Genovese, G. et al. N. Engl. J. Med. 371, 2477–2487 (2014).
Xie, M. et al. Nature Med. 20, 1472–1478 (2014).
Weeks, L. D. & Ebert, B. L. Blood 142, 2235–2246 (2023).
Weeks, L. D. et al. N. Engl. J. Med. Evid. https://doi.org/10.1056/EVIDoa2200310 (2023).
Pasupuleti, S. K. & Kapur, R. Curr. Opin. Hematol. 31, 193–198 (2024).
Belizaire, R., Wong, W. J., Robinette, M. L. & Ebert, B. L. Nature Rev. Immunol. 23, 595–610 (2023).
Zhang, C. R. C. et al. Exp. Hematol. 80, 36–41 (2019).
Zhou, P. et al. Nature 561, 122–126 (2018).
Peled, J. U. et al. N. Engl. J. Med. 382, 822–834 (2020).
Ryzhakov, G. Nature Commun. 9, 3797 (2018).
Competing Interests
The authors declare no competing interests.
Read the paper: Microbial metabolite drives ageing-related clonal haematopoiesis via ALPK1
Read the paper: Microbial metabolite drives ageing-related clonal haematopoiesis via ALPK1
 Age-related blood condition counteracted with a common diabetes drug
Age-related blood condition counteracted with a common diabetes drug
 Childhood leukaemia in Down’s syndrome primed by blood-cell bias
Childhood leukaemia in Down’s syndrome primed by blood-cell bias








